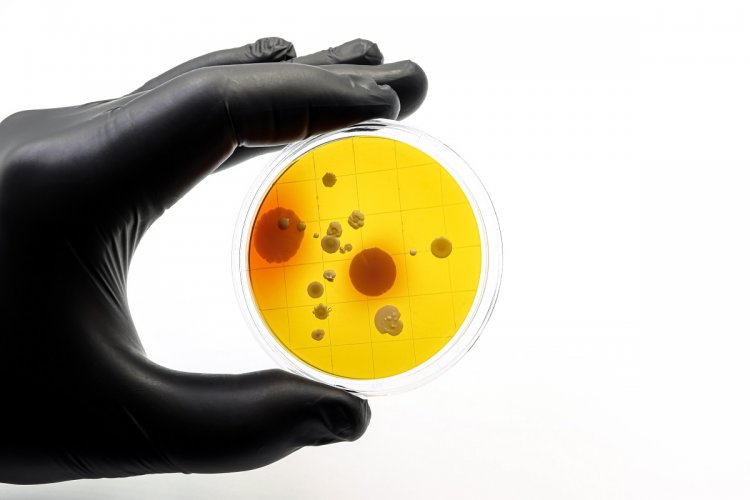

Superbugs in Food: Ανθεκτικά μικρόβια στο πιάτο!! Ο αόρατος κίνδυνος που κρύβεται στο φαγητό μας - Η άγνωστη απειλή στη διατροφή μας!!
Superbugs in Food / Ανθεκτικά μικρόβια στο πιάτο!! Ο αόρατος κίνδυνος που κρύβεται στο φαγητό μας - Η άγνωστη απειλή στη διατροφή μας!!

Superbugs in Food / Ανθεκτικά μικρόβια στο πιάτο!! Ο αόρατος κίνδυνος που κρύβεται στο φαγητό μας - Η άγνωστη απειλή στη διατροφή μας!!
Όλοι γνωρίζουμε τους βασικούς κανόνες υγιεινής για την ασφάλεια τροφίμων, όμως πόσο προετοιμασμένοι είμαστε για έναν αόρατο κίνδυνο που ενδέχεται να ελλοχεύει στα γεύματά μας; Τα ανθεκτικά μικρόβια στο πιάτο μας δεν αποτελούν σενάριο επιστημονικής φαντασίας, αλλά μια υπαρκτή, σιωπηλή απειλή για τη δημόσια υγεία. Η υπερβολική χρήση αντιβιοτικών στην κτηνοτροφία και τη γεωργία έχει οδηγήσει στη δημιουργία υπερμικροβίων (superbugs), τα οποία καταφέρνουν να ταξιδέψουν μέσω της τροφικής αλυσίδας και να φτάσουν στην καθημερινή μας διατροφή. Στο άρθρο που ακολουθεί, αναλύουμε πώς ακριβώς η μικροβιακή αντοχή απειλεί την υγεία μας μέσα από το φαγητό και ποια είναι τα μέτρα προστασίας που πρέπει να λάβουμε ως καταναλωτές.
Ανθεκτικά μικρόβια στο πιάτο: Η άγνωστη απειλή στη διατροφή μας - Πώς αναπτύσσονται και διασπείρονται τα ανθεκτικά μικρόβια σε όλα τα στάδια της τροφικής αλυσίδας
Πολλοί πιστεύουν ότι τα ανθεκτικά μικρόβια αποτελούν κίνδυνο μόνο όταν παίρνουμε αντιβιοτικά και άλλα φάρμακα χωρίς λόγο.
Γνωστή και ως «σιωπηλή πανδημία», η μικροβιακή αντοχή αποτελεί πράγματι σήμερα μία από τις μεγαλύτερες απειλές για την παγκόσμια υγεία.
Ωστόσο, λίγοι σκέφτονται ότι ανθεκτικά μικρόβια αναπτύσσονται και σε όλα τα στάδια της τροφικής αλυσίδας: από τη στιγμή που συλλέγονται οι πρώτες ύλες μέχρι τη στιγμή που μαγειρεύουμε και τρώμε ένα γεύμα.
Σε ποια μικρόβια έχουμε αναπτύξει αντοχή από τη διατροφή μας
Αυτό συμβαίνει λόγω της ευρείας χρήσης αντιβιοτικών και άλλων αντιμικροβιακών φαρμάκων στην κτηνοτροφία, τόσο για την πρόληψη ασθενειών μεταξύ των ζώων που διαβιούν σε συνθήκες συνωστισμού, όσο και για να αναπτυχθούν τα ζώα πιο γρήγορα και να οδηγηθούν για σφαγή.
Αντίστοιχα, μεγάλο μέρος των φαρμάκων αυτών καταλήγει στον υδροφόρο ορίζοντας, επηρεάζοντας έτσι και τις καλλιέργειες.
Οι αποδείξεις βρίσκονται σε περσινή έκθεση της Ευρωπαϊκής Αρχής για την Ασφάλεια των Τροφίμων (EFSA), η οποία εξέτασε την αντοχή που αναπτύσσουν τα ζωονοσογόνα βακτήρια (αυτά που μπορούν να μεταδοθούν από τα ζώα στον άνθρωπο) και τα βακτήρια-δείκτες (αυτά που χρησιμοποιούνται για την έμμεση μελέτη της υγιεινής και της ασφάλειας των τροφίμων).
Η έκθεση επισημαίνει υψηλά επίπεδα αντοχής στη σιπροφλοξασίνη (ciprofloxacin), ένα αντιβιοτικό που χρησιμοποιείται συνήθως στην ανθρώπινη ιατρική, σε βακτήρια όπως το Campylobacter coli. Αυτός ο μικροοργανισμός εντοπίζεται τόσο στους ανθρώπους όσο και στα ζώα εκτροφής, ιδιαίτερα σε κοτόπουλα, γαλοπούλες, μοσχάρια και χοίρους.
Παρόμοια αντοχή έχει ανιχνευθεί και σε ορισμένα στελέχη της σαλμονέλας, όπως αποκαλύπτει το The Conversation.
Ποια είναι τα πιο κοινά ανθεκτικά μικρόβια στο πιάτο μας
Τα ανθεκτικά υπερβακτήρια είναι ικανά να εξαπλώνονται μέσω διαφόρων φορέων – συμπεριλαμβανομένου του νερού άρδευσης, του εδάφους, των γεωργικών προϊόντων και των μονάδων επεξεργασίας, πριν καταλήξουν στο τραπέζι μας.
Μια ευρωπαϊκή μελέτη, που δημοσιεύθηκε πέρσι στο Nature Microbiology, ανέλυσε περισσότερα από 2.000 δείγματα, από ωμό κρέας και τυριά μέχρι τις επιφάνειες που ακουμπάμε τα τρόφιμα. Τα αποτελέσματα είναι εντυπωσιακά.
Κατά τη διαδρομή των τροφίμων από την παραγωγή μέχρι την κατανάλωση, η αντοχή ακόμη και σε γνωστά αντιβιοτικά, όπως η πενικιλίνη και η στρεπτομυκίνη, αναπτύσσεται κυρίως μέσω ανταλλαγής γενετικού υλικού μεταξύ των βακτηρίων που υπάρχουν σε κάθε στάδιο της αλυσίδας.
Ιδιαίτερα σημαντικό ρόλο σε αυτή τη διαδικασία παίζει η λεγόμενη ομάδα ESKAPE (Enterococcus faecium, Staphylococcus aureus, Klebsiella pneumoniae, Acinetobacter baumannii, Pseudomonas aeruginosa και Enterobacter spp.), η οποία περιλαμβάνει βακτήρια που είναι όχι μόνο συχνά ανθεκτικά, αλλά και πολύ ικανά στο να μεταδίδουν αυτή την αντοχή σε άλλα βακτήρια.
Μεταξύ αυτών, ο χρυσίζων σταφυλόκοκκος θεωρείται βασικός «φορέας» ανθεκτικότητας, κυρίως επειδή βρίσκεται φυσιολογικά στο δέρμα και στους βλεννογόνους περίπου του ενός τρίτου των ανθρώπων.

Πώς μεταφέρονται μέσω του φαγητού
Πώς λοιπόν μοιράζονται μεταξύ των μικροοργανισμών οι «οδηγίες» για την επιβίωση από αντιβιοτικά ή απολυμαντικά;
Η διαδικασία αυτή γίνεται μέσω τριών διαφορετικών μηχανισμών:
- Μετασχηματισμός: Το βακτήριο προσλαμβάνει ελεύθερο γενετικό υλικό απευθείας από το περιβάλλον. Σκεφτείτε κάποιον που μαζεύει ένα σημείωμα από το έδαφος και το βάζει στην τσέπη του.
- Μεταγωγή: Το γονίδιο μεταφέρεται μέσω ενός βακτηριοφάγου, ενός ιού των βακτηρίων που λειτουργεί σαν… ταχυδρόμος που παραδίδει μια επιστολή.
- Σύζευξη: Δύο βακτήρια έρχονται σε φυσική επαφή και, όπως δύο υπολογιστές που συνδέονται με καλώδιο, μεταφέρουν πληροφορίες απευθείας το ένα στο άλλο.
Σαν να μην έφταναν αυτά, η βιομηχανία τροφίμων αντιμετωπίζει επίσης το πρόβλημα του σχηματισμού πολυμικροβιακών βιοϋμενίων (biofilms). Πρόκειται για συστάδες μικροοργανισμών που προσκολλώνται σε επιφάνειες και είναι ιδιαίτερα ανθεκτικές σε εξωτερικούς παράγοντες και στις συμβατικές μεθόδους καθαρισμού και απολύμανσης.
Αυτά τα βιοφίλμ μπορούν να φιλοξενήσουν «επίμονα» είδη τα οποία, παρόλο που δεν μπορούν να πολλαπλασιαστούν, αντέχουν στον χρόνο και αποτελούν πραγματικές εστίες μόλυνσης. Μπορούν επίσης να διευκολύνουν τη μεταφορά γονιδίων αντοχής.
Η λύση; Αντιβιοτικά από φυτά
Η σύγχρονη έρευνα εστιάζει πλέον στην αναζήτηση αντιμικροβιακών ουσιών φυτικής προέλευσης, όπως τα αιθέρια έλαια.
Μεταξύ αυτών των ενώσεων ξεχωρίζουν η καρβακρόλη (που βρίσκεται στη ρίγανη και το θυμάρι), το αιθέριο έλαιο μέντας και η κιτράλη (που προέρχεται από εσπεριδοειδή).
Γενικά, αυτοί οι παράγοντες είναι λιγότερο τοξικοί από τα συμβατικά αντιβιοτικά και είναι λιγότερο πιθανό να οδηγήσουν στην ανάπτυξη αντοχής.
Μειώνοντας αποτελεσματικά τα βιοφίλμ και εξαλείφοντας τα βακτήρια που τα σχηματίζουν, θα μπορούσαν να βοηθήσουν στον περιορισμό της χρήσης αντιβιοτικών και στην αναχαίτιση της αύξησης της αντοχής σε αυτές τις ενώσεις.